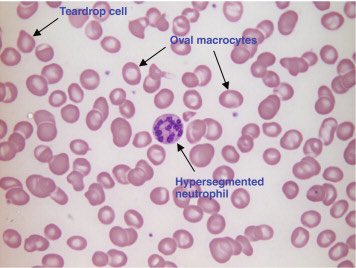

Megaloblastic anemia, thread ⬇️
طيب قبل ما أبتدي براجع معلومة بسيطة قلتها مُسبقاً، اللي هي MCV متوسط حجم الخلية والمعدل الطبيعي من 80-95 لما يكون نورمال normocytic، أقل microcytic، أكثر macrocytic، حلو؟
هنا في Megaloblastic anemia المشكله عندنا إن MCV أكبر من الطبيعي، ف راح أقول تتميز الخلايا الحمراء بإنها Macrocytic والهيموغلوبين فيها طبيعي
ببتدي أتعمق في النوع الأول، مثل ماذكرت فوق إنه الخلايا الحمراء أكبر من الطبيعي بسبب إن عندنا خلل في تصنيع الحمض النووي " DNA “ وبعدها راح يكون عندنا خلل في نخاع العظم وتطلع لنا الخلايا أكبر
ومب بس الخلايا الحمراء اللي بتتأثر لا، حتى granulocytic+ megakaryocytic وراح يؤدي إلى pancytopenia
طيب شنو الفرق بين النوع الأول والثاني؟ الأول لما أسوي مسحة للدم راح أشوف إن الخلايا oval, hypersegmented أما النوع الثاني مو hypersegmented وشكل الخلايا round
إنزين شالأسباب؟ نقص في حمض الفوليك, نقص في فيتامين B12، تسمم الزرنيخ وغيره
معلومة مهمه مفروض أذكرها في البدايه : فيتامين B12, حمض الفوليك مهمين جداً في تصنيع ال DNA ف هنا لما يكون عندي نقص فيهم راح يكون فيه خلل في تصنيع ال DNA
طيب شنو الأسباب اللي تؤدي إلى نقص فيتامين B12؟ pernicious anemia" راح أشرحها بعد شوي " ، مرض مناعي ، بعض الأدوية راح تتعارض مع إمتصاص فيتامين B12
طيب نجي لحمض الفوليك يمتص عن طريق small intesine، أسباب نقصه : ما أخذه بالكمية الكافيه، فيه مشكله في الإمتصاص, اللي يشربون الخمور
pernicious anemia ? هنا يكون فيه نقص في إنتاج Intrinsic factor اللي تساعد على إمتصاص فيتامين B12
طيب آخر شيء التشخيص، راح نسوي مسحة للدم، تعداد كامل للدم، إختبارات كيميائية، Bone marrow examination, specail test
?CBC: MCV& MCH ⬆️ high
RBC&WBS ⬇️ low
reticulocyte count ⬇️
RBC&WBS ⬇️ low
reticulocyte count ⬇️
? chemial test : ELISA
serum folate ⬇️ , serum B12 ⬇️, Red cell folate level: normal
serum folate ⬇️ , serum B12 ⬇️, Red cell folate level: normal
Tretment : أعالج السبب الرئيسي + تغير نظام الأكل
End . ?
@Rattibha رتب
Loading suggestions...